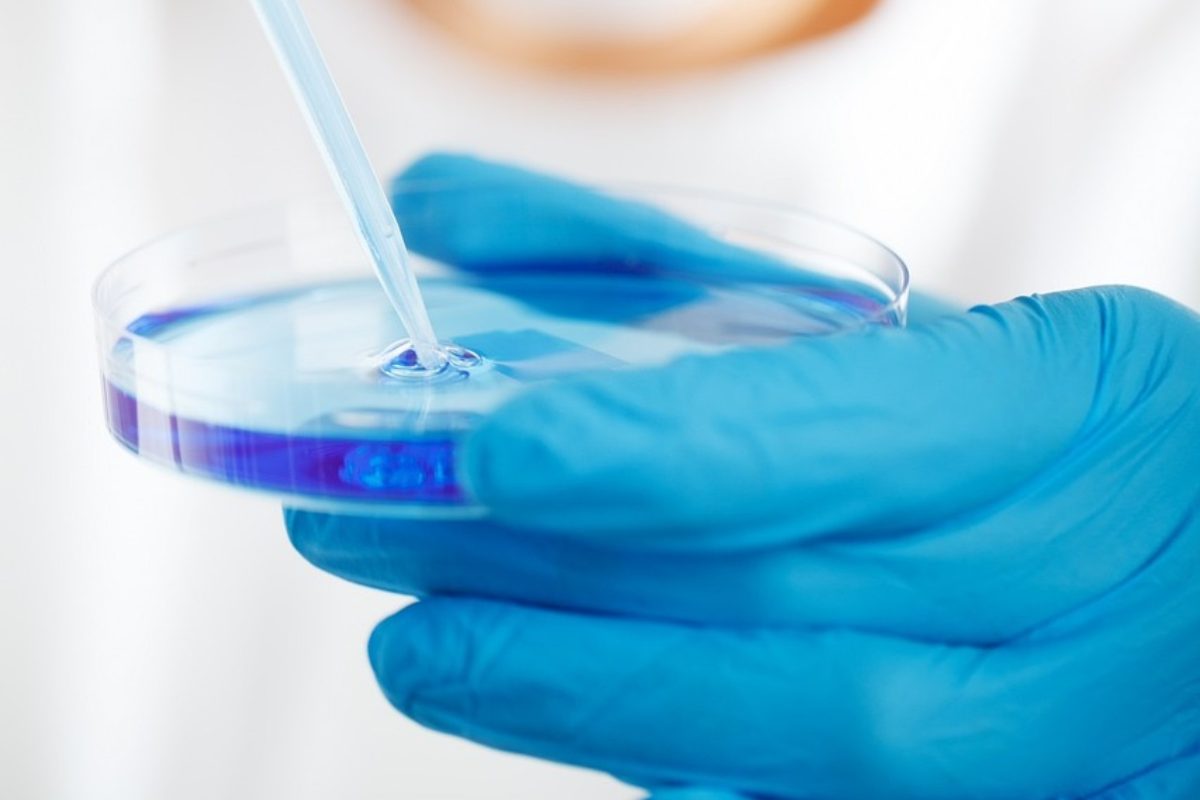

Una scoperta che potrebbe cambiare la lotta contro malattie molto gravi: ecco il farmaco contro obesità e colesterolo
Gli scienziati sono convinti di aver creato le basi per un nuovo rivoluzionario farmaco che possa giocare un ruolo fondamentale contro questi fattori che, a volte, provocano degli effetti letali per milioni di persone nel mondo. La svolta per una serie di patologie molto serie, causate dall’obesità e dal colesterolo.
Questo perché, come ben sapete, obesità e colesterolo sono nemici della nostra salute e si alimentano vicendevolmente. Lo fanno a causa di una alimentazione poco sana, anzi, sregolata, ma anche nei soggetti che portano avanti uno stile di vita non salutare, con comportamenti troppo sedentari.
L’obesità, infatti, è un fattore fondamentale per l’insorgenza di malattie molto gravi come quelle neoplastiche e tumorali. Non solo. Come è noto, è collegata all’insorgenza di una malattia grave e invalidante come il diabete. E le persone in sovrappeso (e, a volte, in netto sovrappeso) hanno molte più probabilità di sviluppare malattie di tipo cardiaco e cardiovascolare. Il colesterolo, come sapete, è un grasso presente naturalmente nel sangue, ma che può essere fatale quando è in quantità eccessive, perché rischia di ostruire il passaggio del sangue in vene e arterie.
Insomma, non stiamo dicendo niente di nuovo, soprattutto a chi soffre di queste drammatiche problematiche. Ma diremo qualcosa di nuovo (ed è un’ottima notizia) dandovi conto del fatto che forse, oggi, un farmaco potrebbe cancellare definitivamente colesterolo e obesità. Ecco le novità da parte della scienza.
Un farmaco contro obesità e colesterolo
L’importante passaggio scientifico si deve ai ricercatori dell’Università del Massachusetts Amherst negli Stati Uniti, con uno studio pubblicato su PNAS Nexus. Tutto questo dimostra, ancora una volta, l’importanza della ricerca (e del sostegno alla stessa), dato che i fondi necessari sono arrivati grazie a una startup, Cyta Therapeutics, creata con l’obiettivo principale di sviluppare piattaforme di somministrazione innovative. Si tratta di un approccio molto semplice, di tipo selettivo, che possa indirizzarsi verso obiettivi diversi.

Gli scienziati sono convinti di poter invertire la malattia somministrando farmaci direttamente nel fegato e riducendo al minimo gli effetti collaterali. Tutto questo tramite un trasportatore di nanogel, che potrebbe essere un metodo rivoluzionario per trattare con successo la malattia del fegato grasso, il diabete di tipo 2 e il colesterolo alto.
Per ora gli esperimenti sono stati effettuati sui topi (che, come è noto, hanno una struttura genetica molto simile a quella degli esseri umani) e hanno dimostrato i roditori trattati così hanno perso il peso guadagnato, senza alcun tipo di effetto collaterale. Ma non solo il loro peso è tornato alla normalità, ma anche i livelli di colesterolo sono diminuiti e i livelli dannosi di infiammazione del fegato si sono attenuati.